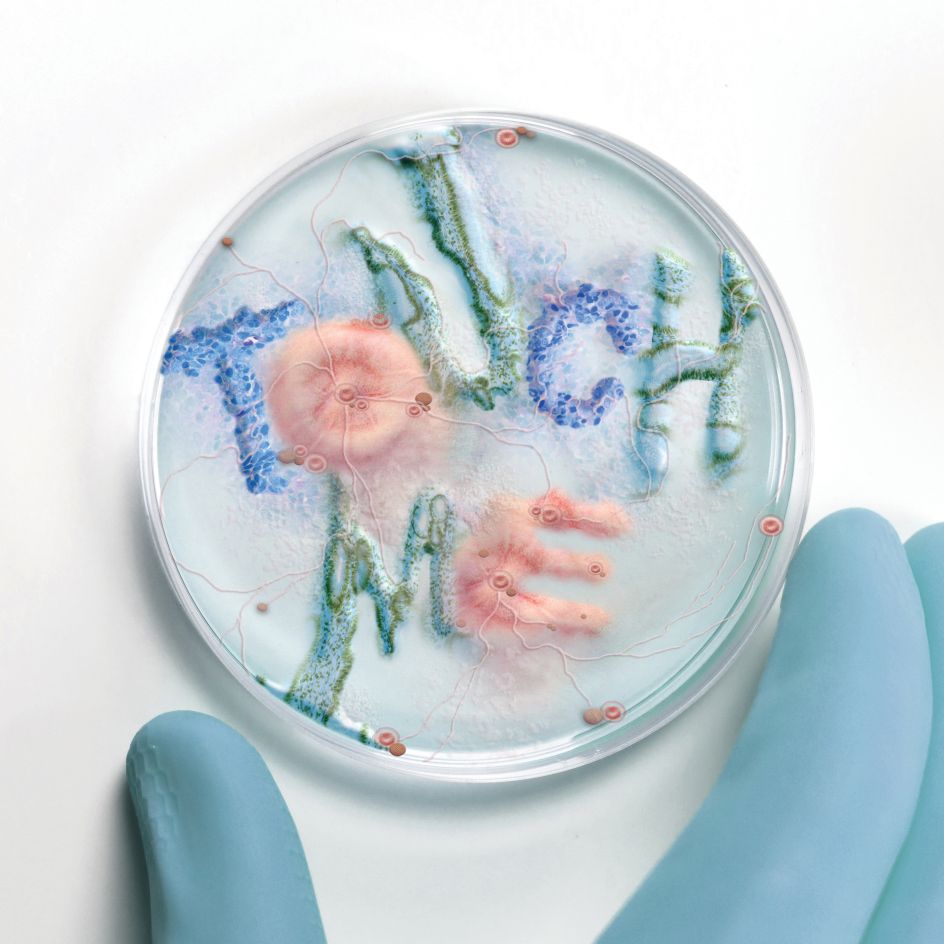
Innovation Award Winner: Typographic Bacteria © Xavier Segers

Fatinha Ramos crowned overall 'professional' winner in this year's World Illustration Awards
Antwerp-based illustrator and visual artist Fatinha Ramos has been named the Professional winner of the World Illustration Awards for 2021, scooping the overall prize for her moving editorial piece on the subject of suicide. Here, we reveal more of her winning project, along with the rest of this year's winners.

Professional Overall Winner: The Other US Epidemic © Fatinha Ramos
Every year, the Association of Illustrators partners with the Directory of Illustration to host the World Illustration Awards, bringing us inspiring work from some of the best artists and illustrators in the industry today. And this year is no exception. Despite a pandemic, the line of established and emerging shortlisted creatives has once again shown immense talent.
Fatinha Ramos scooped the overall prize in the Professional category for her editorial illustration for Scientific American and the professional category winner in Professional Children's Publishing and in Editorial. She is among those to be announced this evening by the AOI, including 20 category winners, spanning everything from advertising and book covers to children's publishing and product packaging, 20 highly commended projects, four cross-category and two overall winners – all selected from a shortlist of 200 projects, drawn from over five thousand entries from 82 countries around the world.
Speaking of her winning work, Fatinha says: "This image focuses more on the emotional part of suicide and can be interpreted in two ways: from the perspective of the person who stays, and from the perspective of the person who goes... I want to strike an emotional chord with people with this image."

New Talent Overall Winner: Cabinet of Curiosities © Dani Choi
Alongside the Portuguese illustrator is Dani Choi, who has been crowned overall winner in the New Talent category. The Brooklyn-based artist, who is represented by Dutch Uncle, is a graduate of the School of Visual Arts in New York and has Apple and Bloomberg amongst her many clients. Her winning piece, Cabinet of Curiosities, was for Atomix, a Korean fine dining restaurant located in Manhattan, and consists of twelve illustrations for menu cards to be served with a ten-course menu dish. "The menu cards are gifted to customers as a kind of souvenir, so I decided to create images representative of the Korean culture to make the cultural experience at the restaurant more memorable," Dani explains. "The images were inspired by Sip-Jang-Saeng, ten or more Korean traditional symbols of longevity and prosperity of life in harmony with nature. I designed the menu cards in a way that each card can stand solely as an image, and when all twelve images are put together at the end of the entire course, they create a new image, a cabinet filled with the twelve symbols."
Other New Talent winners include Marie Doerfler for Advertising and her illustration for Bernhard Müller GmbH. She was asked to create a series of illustrations of people and animals relating to furniture design in a "playful and imaginative way". While Sojung Kim-McCarthy was the Professional winner in the same category for a range of illustrated postcards to help promote the new film, Minari. "It's the story of a Korean-American family trying to build a new life," she explains. "The brief was to bring nostalgic Americana mood and Asian immigrant experiences together. Iconic American paintings by Andrew Wyett and Norman Rockwell as well as the heroic image of James Dean were used as references."

New Talent Winner – Advertising: Bernhard Müller GmbH © Marie Doerfler

Professional Winner – Advertising: Minari Movie Postcards © Sojung Kim-McCarthy
Under Alternative Publishing, London-based illustrator and host of On Design podcast Justyna Green was also recognised for her project, Living with Endometriosis for WeTransfer's WePresent platform. "The comic presented a new and engaging way of opening up a discussion about chronic conditions and mental health struggles," she says. The piece was well-received, with women getting in touch with Justyna to express how much the work resonated with them. In the same category, Amy Moss won the Professional award for her From London Heading South zine.
In the Editorial category, Jialei Sun found success as the New Talent winner for her personal illustrations she made during the pandemic: "Spending almost a whole year at home, I found I spend much less time on shopping. The feeling of not adding new things to my life made me want to make some works to satisfy my shopping desire. So I combined things I want to buy and put them into my illustrations," she explains.

New Talent Winner – Alternative Publishing: Living With Endometriosis © Justyna Green

New Talent Winner – Editorial: Collection © Jialei Sun
Another creative to explore the impact of lockdowns was Jason Chuang, an illustrator and storyteller based in Taiwan and the UK. He created a beautiful series titled Days Spent in Isolation. His work helped him win the people's choice category, officially named AOI Members Award Winner. "Under the impact of Covid-19, I have spent an unusually vast amount of time indoors, which I have used to self-reflect and explore ways to convey my experiences through various visual metaphors. Emancipating ideas and directing my emotions out from my body is both a meditative and healing condolence for me during this strange time," he says.
While Maryam Khaleghiyazdi was named the Professional winner in the Exploration category for her Morphing Shadow artwork, Dominic Bodden was named the New Talent winner in the same field. His Portraits of Westlake impressed the judges for a series of illustrations that investigates the "impact of gentrification on the neighbourhood of Westlake, Los Angeles, and the ways local families and businesses are adapting to the many changes in the community," as Dominic explains. "Emphasis is placed on the ways tradition and innovation intersect when people are trying to survive."

AOI Members Award Winner: Days Spent in Isolation © Jason Chuang

New Talent Winner – Exploration: Portraits of Westlake © Dominic Bodden
Elsewhere, the Innovation Award and Professional Science & Technology prize went to Xavier Segers for his Typographic Bacteria – a pretty timely project given the last two years. "When the first lockdown hit, all of my freelance projects dried up for two months," he says. "This gave me time to experiment. This series was one of those experiments inspired by the constant news reports on Covid-19. Politicians, scientists, and the media had so much to say about the virus that I thought, why not give the pandemic its own voice by injecting it in typographic bacteria and listening to what it has to say?"
Argentinian illustrator Iris de Luz, meanwhile, won the DI Award Winner and was crowned overall Professional in the Exploration category for her own Personal Exploration project. She used photos of different parts of flower petals, seaweed, and other natural textures – precious stones, fruits, sweets and 3D vector shapes to create a series of artworks that later became prints.
The winners were announced during an online ceremony by the AOI this evening. You can discover more at theaoi.com or follow the awards on Instagram.

DI Award Winner: Personal Exploration © Iris de Luz
Innovation Award Winner: Typographic Bacteria © Xavier Segers






















